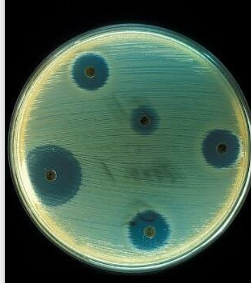
Descubrimiento de la Penicilina 1928

-
Fue un movimiento europeo que se dio a finales del siglo XIV y en los primeros años del siglo XVI, que transformó lo filosófico cultural e intelectual con el objetivo de perfeccionar al hombre.
-Descubrimientos
-Racionalismo
-Humanismo
-Naturaleza -
 Dicho pensamiento se basó en la agrupación de ciertos valores del ser humano. Esta corriente se oponía al pensamiento teológico, pues ellos defendían el antropocentrismo, donde el hombre era el centro de todo y no Dios, es allí cuando empieza a predominar la razón sobre la fe.
Dicho pensamiento se basó en la agrupación de ciertos valores del ser humano. Esta corriente se oponía al pensamiento teológico, pues ellos defendían el antropocentrismo, donde el hombre era el centro de todo y no Dios, es allí cuando empieza a predominar la razón sobre la fe. -
Se planteó un modelo de conocimiento mucho más puro, se defiende la idea de usar la razón, se reformula el modelo de la educación, se desarrollan ciencias como la dramática, la retórica, la literatura, la filosofía, la moral y la historia.
-
 La imprenta fue inventada por Johannes Gutenberg y con esta permitió la distribución de libros, panfletos, y pancartas con el fin de propagar dichas noticias o mensajes críticos a personas y lograr abarcar a muchos más.
La imprenta fue inventada por Johannes Gutenberg y con esta permitió la distribución de libros, panfletos, y pancartas con el fin de propagar dichas noticias o mensajes críticos a personas y lograr abarcar a muchos más. -
 Fue un teólogo y fraile católico agustino que comenzó e impulsó la Reforma protestante en Alemania y cuyas enseñanzas se inspiraron en la doctrina teológica y cultural denominada luteranismo. Sus ideas eran muy radicales.
Fue un teólogo y fraile católico agustino que comenzó e impulsó la Reforma protestante en Alemania y cuyas enseñanzas se inspiraron en la doctrina teológica y cultural denominada luteranismo. Sus ideas eran muy radicales. -
 El descubrimiento de américa, acontecimiento histórico del 12 de octubre de 1492, con la llegada a América de una expedición capitaneada por Cristóbal Colón por mandato de los Reyes Católicos, Isabel de Castilla y Fernando de Aragón.
El descubrimiento de américa, acontecimiento histórico del 12 de octubre de 1492, con la llegada a América de una expedición capitaneada por Cristóbal Colón por mandato de los Reyes Católicos, Isabel de Castilla y Fernando de Aragón. -
El humanismo se caracteriza por reconocer y aceptar la diferencia como elemento sustantivo en la realidad social, trajo hechos positivos en la economía y la tecnología
Los rasgos más generales:
-El antinatalismo
-El pesimismo
-Sífilis
-Tuberculosis
Personajes representativos:
-Friedrich Wilhelm Nietzsche
-Arthur Schopenhauer.
Problemáticas:
-Renacimiento de revoluciones liberales y burguesas
-Desarrollo de nacionalismo
-Nacimiento -
 Descubren los primeros manaderos de petróleo1810
Descubren los primeros manaderos de petróleo1810
Infantas
El primer pozo productor.
Nace Ecopetrol
la compañía de la nación. 1951
Se empieza a hablar sobre fracking. -
 Su filosofía, concebida muchas veces como un «pensar hasta el final» de la filosofía de Kant, es deudora de Platón y
Su filosofía, concebida muchas veces como un «pensar hasta el final» de la filosofía de Kant, es deudora de Platón y
Spinoza, sirviendo además como puente con la filosofía oriental, en especial con el budismo, el taoísmo y el vedanta,
afirmando principios como el ascetismo y la noción de la apariencia del mundo. -
 La Revolución Industrial marcó un antes y un después en la historia de la humanidad.
La Revolución Industrial marcó un antes y un después en la historia de la humanidad.
Especialmente porque su impacto se extendió a todos los ámbitos de la sociedad, trae cambios significativos en la economía y la tecnología; fue un proceso de profundas transformaciones económicas, sociales, culturales y tecnológicas. y tuvo su origen en Inglaterra, se desarrolló entre 1760 y 1840 -
 Nietzsche escribió sobre temas tan diversos como el arte, la filología, la historia, la religión, la ciencia o la tragedia. Hizo
Nietzsche escribió sobre temas tan diversos como el arte, la filología, la historia, la religión, la ciencia o la tragedia. Hizo
una crítica de la cultura, la religión y la filosofía occidental mediante la genealogía de los conceptos que las integran,
basada en el análisis de las actitudes morales (positivas y negativas) hacia la vida. -
Aumento el número de personas que empezaron estudios y por ende el número de lectores, también nace la biblioteca pública tal como se le conoce actualmente.
-
Es una filosofía que orienta la manera de formar al hombre, enfatizando la capacidad de éste para interpretar y entender la realidad que lo rodea, para ello determina como base fundamental la condición humana. Además es explícita la relación del hombre en comunidad como factor básico para desarrollar una sociedad democrática. Se renueva el interés por las problemáticas acerca de la naturaleza y la moralidad del poder político, Las artes y la cultura sufrieron una sacudida por buscar la verdad
-
 El manejo del aeroplano fue el objeto de la primera patente de los hermanos Wright, presentado en marzo de 1903. El 17 de diciembre de aquel mismo año lograron su gesta más conocida, elevarse en su primer aparato propulsado por hélices, el Wright Flyer I.
El manejo del aeroplano fue el objeto de la primera patente de los hermanos Wright, presentado en marzo de 1903. El 17 de diciembre de aquel mismo año lograron su gesta más conocida, elevarse en su primer aparato propulsado por hélices, el Wright Flyer I. -
 Físico alemán, fue considerado el científico más importante del siglo XX escribió la teoría de la relatividad restringida, la cual se publicó en 1905 "La vida es como andar en bicicleta. Para mantener el equilibrio, debes seguir moviéndote"
Físico alemán, fue considerado el científico más importante del siglo XX escribió la teoría de la relatividad restringida, la cual se publicó en 1905 "La vida es como andar en bicicleta. Para mantener el equilibrio, debes seguir moviéndote" -
 Fue un abogado, activista contra el apartheid, político y filántropo sudafricano que presidió su país de 1994 a 1999. Mandela, también conocido como Madiba en referencia a su tribu, recibió el Premio Nobel de la Paz en 1993 por su compromiso con los derechos humanos . Icono de la lucha contra el apartheid, al que derrotó, antiguo líder del Congreso Nacional Africano, primer presidente negro de su país y Premio Nobel de la Paz.
Fue un abogado, activista contra el apartheid, político y filántropo sudafricano que presidió su país de 1994 a 1999. Mandela, también conocido como Madiba en referencia a su tribu, recibió el Premio Nobel de la Paz en 1993 por su compromiso con los derechos humanos . Icono de la lucha contra el apartheid, al que derrotó, antiguo líder del Congreso Nacional Africano, primer presidente negro de su país y Premio Nobel de la Paz. -
Alexander Fleming hizo crecer el moho en un cultivo puro y descubrió que producía una sustancia que mataba a varias bacterias causantes de enfermedades. Identificó el moho como perteneciente al género Penicillium y, después de algunos meses de llamarlo "jugo de moho", el 7 de marzo de 1929 llamó a la sustancia penicilina.
Alexander Fleming hizo crecer el moho en un cultivo puro y descubrió que producía una sustancia que mataba a varias bacterias causantes de enfermedades. Identificó el moho como perteneciente al género Penicillium y, después de algunos meses de llamarlo "jugo de moho", el 7 de marzo de 1929 llamó a la sustancia penicilina. -
 Defensor de los derechos humanos, reconocido como uno de los mas grandes políticos y espirituales del siglo XX, líder de campañas a escala nacional para mitigar la pobreza, expandir los derechos de las mujeres, armonía religiosa y étnica, y eliminar las injusticias del sistema de castas, conocido como el padre de la nación en india. Gracias a la campaña de resistencia civil, no violencia contra el gobierno británico de la india, mahatma logro su independencia en 1947
Defensor de los derechos humanos, reconocido como uno de los mas grandes políticos y espirituales del siglo XX, líder de campañas a escala nacional para mitigar la pobreza, expandir los derechos de las mujeres, armonía religiosa y étnica, y eliminar las injusticias del sistema de castas, conocido como el padre de la nación en india. Gracias a la campaña de resistencia civil, no violencia contra el gobierno británico de la india, mahatma logro su independencia en 1947 -
 En esta última etapa de la humanidad, centrada en la economía del mercado y la productividad, el desarrollo del conocimiento ha ganado mucho terreno. La sociedad de hoy es digital. Esto significa mucho más que el uso de aparatos electrónicos e internet. En la actualidad, las tecnologías digitales modificaron las prácticas y las formas de hacer de los seres humanos; en cambio, las tecnologías digitales también están modificando profundamente las formas de pensar y de sentir.
En esta última etapa de la humanidad, centrada en la economía del mercado y la productividad, el desarrollo del conocimiento ha ganado mucho terreno. La sociedad de hoy es digital. Esto significa mucho más que el uso de aparatos electrónicos e internet. En la actualidad, las tecnologías digitales modificaron las prácticas y las formas de hacer de los seres humanos; en cambio, las tecnologías digitales también están modificando profundamente las formas de pensar y de sentir.
-
Este concepto fue desarrollado en la segunda mitad del siglo XIX y nos ayuda a comprender la evolución del comportamiento humano en la actualidad. Dentro del caos que puede llegar a ser un proceso de digitalización, Joan Clotet ayuda a individuos, directivos de personas y organizaciones a tomar conciencia y mejores decisiones, a conocerse mejor, crecer y ayudar a otros dejando huella humana y positiva en esta era digital
-
 El marketing digital es la aplicación de las estrategias de comercialización llevadas a cabo en los medios digitales.
El marketing digital es la aplicación de las estrategias de comercialización llevadas a cabo en los medios digitales.
El e-marketing o marketing digital nació entre 1990 y 1994, coincidiendo con el lanzamiento de “Archie”, el primer motor de búsqueda. En 1993, aparece el primer banner de publicidad web seleccionable. Un año después se da la primera transacción comercial electrónica en Netmarket -
 Con la era digital aparecen nuevas técnicas y nuevas formas de comunicación, se crean las bibliotecas virtuales que enriquecen aun mas la educación y la sociedad en general.
Con la era digital aparecen nuevas técnicas y nuevas formas de comunicación, se crean las bibliotecas virtuales que enriquecen aun mas la educación y la sociedad en general.
-Modelos socio culturales que no logran superar barreras a partir de la tecnología -
 Conocida como red sensorial-emotiva, porque permite al usuario la interacción desde experiencias más emocionantes. Facilita que la comunicación sea mucho más sencilla, gracias a que es posible conocer e interactuar con muchas personas. La búsqueda de información se vuelve mucho más sencilla. Es posible encontrar diversidad de puntos de vista. La nueva versión no facilita actualizaciones y mejoras. Se necesita de alta resolución para manejar las barras.
Conocida como red sensorial-emotiva, porque permite al usuario la interacción desde experiencias más emocionantes. Facilita que la comunicación sea mucho más sencilla, gracias a que es posible conocer e interactuar con muchas personas. La búsqueda de información se vuelve mucho más sencilla. Es posible encontrar diversidad de puntos de vista. La nueva versión no facilita actualizaciones y mejoras. Se necesita de alta resolución para manejar las barras. -
 La forma en que hoy las nuevas generaciones procesan la información, en que la usan y la desechan, el manejo de los afectos y de las relaciones interpersonales, el que sea más fácil contactar y hacer amigos al otro lado del mundo, desconociendo al vecino, son muestras de un profundo cambio en la cultura y la sociedad. La manera de entendernos como humanos es distinta a la de hace apenas 30 años.
La forma en que hoy las nuevas generaciones procesan la información, en que la usan y la desechan, el manejo de los afectos y de las relaciones interpersonales, el que sea más fácil contactar y hacer amigos al otro lado del mundo, desconociendo al vecino, son muestras de un profundo cambio en la cultura y la sociedad. La manera de entendernos como humanos es distinta a la de hace apenas 30 años.
-El remplazo de los humanos por maquinas
-Internet
-Redes sociales
-Computadores
Looking for a timeline maker?
Create timelines for projects, roadmaps, history, lessons, legal cases, and stories with Timetoast. Timetoast is a timeline maker for work, school, research, and stories.
